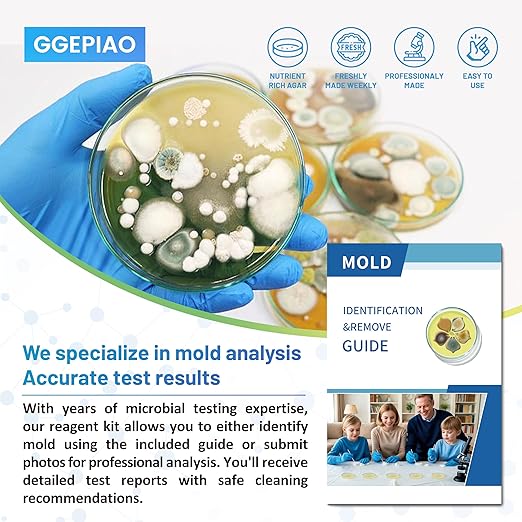

Cleanyra
Mold Test Kit for Home,14 Simple Detection Tests,Test HVAC System,Home Surfaces, Indoor Air Quality Testing,DIY Mold Detector,Includes Detailed Mold Identification Guide,Black Mold Testing kit
Mold Test Kit for Home,14 Simple Detection Tests,Test HVAC System,Home Surfaces, Indoor Air Quality Testing,DIY Mold Detector,Includes Detailed Mold Identification Guide,Black Mold Testing kit
Couldn't load pickup availability
About This
- 14 Complete Mold Testing Kit - This DIY home mold test kit includes 14 individual tests, allowing you to conduct thorough and extensive mold assessments throughout your home. Ideal for testing multiple areas, ensuring no spot is left unchecked
- Three Testing Methods for Comprehensive Analysis - It tests for a variety of molds, including common household varieties. Test room air, HVAC systems, and any household surface, such as walls, showers, cars, sinks, and other mold-prone areas
- Fast and Reliable Mold Detection - This mold test kit for home includes a mold identification guide, delivering quick and reliable results. Easily identify and understand the type of mold present in your home, enabling prompt action. We also offer free laboratory analysis—simply send us photos of the mold, and our team will analyze it for you 24/7
- Ideal for Home Safety - Our home mold testing kit helps monitor your home environment for mold presence. Regular testing assists in maintaining a cleaner living space
- Discover Household Molds - Test room air, HVAC systems, and any household surface in depth. This air mold test kit is designed for home or office use. Results may be observed within 2-4 days under proper use. Identify mold types and their presence in your environment